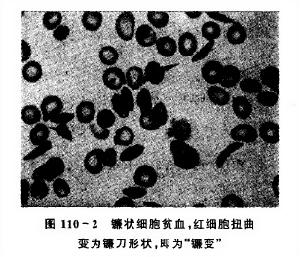
（圖）鐮狀細胞貧血眼部病變

病因
SS型患者90%~100%有血紅蛋白S,鐮狀細胞使其微循環內血流變慢而導致疾病的發生。
發病機制正常紅細胞血紅蛋白為A,呈兩面凹的圓盤,柔軟有彈性 可變形,容易通過毛細血管。鐮狀細胞血紅蛋白為S或C,呈新月形像鐮刀 特別是在低氧狀態下更易鐮變。這種鐮變紅細胞比正常紅細胞硬,不易變形 故易堵塞視網膜小動脈 特別是周邊部小動脈 造成視網膜缺血。因組織缺氧更易促使紅細胞鐮變,因而造成惡性循環。由於血管堵塞造成出血 這種出血在修復過程中刺激視網膜色素上皮肥大、增殖和移行,與含鐵血黃素及巨噬細胞混雜在一起形成黑旭日飾針斑。視網膜閃光點狀沉著物可能為含鐵血黃素在吸收過程中分離成的小碎片構成。血管樣條紋可能因溶血性貧血致慢性鐵質沉著在Bruch膜上致膜破裂形成。
流行病學
鐮狀細胞貧血以中非和西非黑色人種多見,發病率可高達20%~40%。移居美洲的黑人也有發生。在美國黑人中的發病調查,AS為8%;AC為2%~3%;SS為0.2%~0.4%;SC為0.1%;S Thal為0.03%。中國長江以南省份偶有散發病例,但視網膜病變幾乎未見有報告。
臨床表現
鐮狀細胞貧血眼部病變
鐮狀細胞貧血眼部病變分為增殖型和非增殖型2類。其主要病變為視網膜缺血及其並發症,這也是其他血管病如糖尿病性視網膜病變、視網膜靜脈阻塞, 早產兒視網膜病變最常見的特徵。
1.增殖性鐮狀視網膜病變(proliferative sickle retinopathy,PSR) 共分為5期:
(1)小動脈阻塞:病變位於視網膜周邊部,小動脈阻塞呈銀絲狀或白線狀, 小靜脈回流也受阻,形成周邊無灌注區,該區視網膜呈灰棕色,組織模糊不清,與正常橘紅色眼底呈明顯對比。後極部小血管也有異常,特別是黃斑區和周圍黃斑區血管受累, 有微血管瘤樣改變, 小動脈節段性膨大,小靜脈迂曲呈環狀,黃斑中心無血管區擴大,可大於正常2倍。圍繞無血管區尚可有病理性無血管區出現,表示毛細血管閉塞。
(2)動靜脈短路:在小動脈閉塞處,位於動脈側的毛細血管膨大,並與靜脈交通,形成動靜脈交通支,常位於無灌注區和灌注區之間。螢光血管造影見這些動靜脈短路管壁不滲漏。
(3)新生血管增殖:新生血管最常發生在視網膜周邊部顳上方,其次為顳下、鼻上和鼻下方視網膜, 在動靜脈短路附近 從小動脈閉塞處長出新生血管,呈扇形或團扇狀長入無灌注區,類似其他血管病的新生血管, 早期新生血管較少,僅有1支小動脈供應,隨時間推移可發展為多支小動脈供應,或附近又長出另一團新生血管, 螢光血管造影有大量螢光素滲漏, 從分型看,新生血管在SC病發病率最高,占59%~92%,其次為Sthal病,占33% 其他類型為10%。
(4)玻璃體積血:新生血管開始平行於視網膜面生長,以後穿破內界膜經玻璃體基部直達玻璃體中心,並有漏出液滲入視網膜。新生血管可反覆發作玻璃體積血,常被誤診為Eales病, 對黑色人種應想到有本病的可能。有時新生血管由於營養小動脈自發梗死而退縮,不發生玻璃體積血。自發梗死約占49%。
(5)視網膜脫離:由於新生血管增殖,機化膜或條索的收縮和牽拉 鄰近血管膜的視網膜形成破孔,呈卵圓形或馬蹄形,致視網膜脫離。大多數發生在SC的患者。
2.非增殖鐮狀視網膜病變(nonproliferative sickle retinopathy) 非增殖病變包括以下幾種:①周邊部和(或)後極部視網膜靜脈迂曲擴張;②黑旭日飾針斑(black sunbursts),其特點是在視網膜赤道部有0.5~2PD大小的邊界清楚的黑色斑,類似視網膜脈絡膜瘢痕,但其邊界不整齊呈星形或針形 很像嵌有寶石的旭日形飾針;③閃光點狀沉著物(refractile deposits),在病變附近有閃亮的顆粒狀小點沉著,類似膽固醇結晶,但並不是類脂質;④鮭斑出血(salmon-patch hemorrhage),出血進入內界膜下或視網膜內,偶可進入視網膜色素上皮和光感受器之間 呈卵圓形,0.75~1PD的紅色斑,顏色由粉紅色變成橙紅色, 最後變成白色;⑤其他眼部症狀,可有結膜血管呈節段狀 偶可合併有血管樣條紋,或視網膜動脈或靜脈阻塞。
併發症
本病在病情穩定時,患者可耐受貧血及其他臨床症狀;但當病情突然加重時,稱“鐮狀細胞危象”,則有嚴重臨床表現,甚至導致死亡。感染、代謝性酸中毒、低氧條件可能誘發危象,但有時難以發現明顯誘因。根據臨床表現特徵的不同,可將鐮狀細胞危象分為5型:梗死型(疼痛型)再生障礙型,巨幼細胞型,脾滯留型,溶血型。
1.梗死型危象系最常見的一種危象,鐮變的僵硬紅細胞阻塞小血管;組織缺氧,重者導致組織壞死血管梗死可發生於任何部位,但梗死引起疼痛的部位最常見於四肢骨骼,尤以膝部及膝部以下多見其次是胸背部及腹部疼痛常為發作性疼痛可伴有發熱,輕者1~2天自行緩解,重者持續時間較長發作頻度不一;可為數天1次,也可為數年1次。脾梗死是引起腹痛的常見原因多次脾梗死形成大量瘢痕組織可使脾臟變小,稱自身脾切除。部分病人腹痛與慢性溶血引起的膽石症有關,此時血清膽紅素會升高。此型危象發作時貧血常常並不加重。
2.再生障礙型危象貧血突然加重,網織紅細胞顯著減少甚或消失,骨髓增生低下。感染尤其是微小病毒(parvovirus)感染是常見誘發因素。
3.巨幼細胞型危象妊娠患者易發生此型危象,葉酸缺乏是主要原因。嚴重貧血伴有巨幼細胞貧血特徵是本型的主要臨床表現。
4.脾滯留型危象此型危象多見於兒童患者,也可見於脾顯著增大的成年患者。主要臨床表現是血紅蛋白的濃度陡然下降。在幼年患兒可成為致死原因。
5.溶血型危象此型危象不常見。當本病患者合併其他疾患(如G6PD缺乏)時,易發生溶血危象。臨床表現為貧血加重黃疸、網織紅細胞數增多常發生溶血者易有膽石症。
診斷:
根據實驗室檢查結果及臨床表現,可以確診。
檢查
血液常規檢查及遺傳學檢查。
眼底檢查可以發現缺血性病變及其併發症。
治療
閉新生血管為治療的關鍵,可採用氬雷射或冷凍治療 氬雷射治療88%~95%病例新生血管完全封閉。也有報告氬雷射治療後,26%的新生血管完全退縮,57%部分退縮,17%穩定。已發生視網膜脫離者,可作鞏膜環扎術 但應注意鐮狀細胞貧血的SC患者作此手術,有71%發生眼前節缺血,而無鐮狀貧血的眼僅有3%發生。故手術時應採取預防措施,如輸血、給氧、降低眼壓、避免牽拉或離斷直肌等。
治療及預後
 鐮狀細胞貧血眼部病變
鐮狀細胞貧血眼部病變封閉新生血管為治療的關鍵,可採用氬雷射或冷凍治療。氬雷射治療88%~95%病例新生血管完全封閉, 也有報告氬雷射治療後 26%的新生血管完全退縮 57%部分退縮17%穩定。已發生視網膜脫離者,可作鞏膜環扎術,但應注意鐮狀細胞貧血的SC患者作此手術,有71%發生眼前節缺血 ,而無鐮狀貧血的眼僅有3%發生。故手術時應採取預防措施,如輸血、給氧、降低眼壓、避免牽拉或離斷直肌等。
UniversityofPennsylvaniaSchoolofMedicine的研究人員鑑別出一種在所有人類中表達的胚胎蛋白,這個蛋白在小鼠中表達能顯著降低細胞鐮刀型貧血的症狀。這個發現為鐮刀型細胞貧血病的治療提供潛在的新療法。這個結果發表在4月的NatureMedicine上。
鐮刀型細胞貧血是一種遺傳的慢性貧血症,表現為紅血球形態失常,劇烈疼痛,未成年夭折。這是由於病人體內製造血紅蛋白的基因的一個編碼錯誤造成的,血紅蛋白是紅血球攜帶氧氣在體內運輸的主要成分。錯誤的基因編碼一個異常的血紅蛋白,導致紅血球形態失常成鐮刀型,往往會阻塞毛細血管,進一步導致疼痛、中風、心臟病發作、腎功能喪失、甚至早夭。
儘管鐮刀型貧血無法治癒,但還是有治療方法的,包括抗癌藥物hydroxyurea,輸血,骨髓移植等。Hydroxyurea廣泛用於重新激活gamma球蛋白的產生,替代血紅蛋白中的失活組分――beta球蛋白。雖然這種方法不能治癒這種疾病,卻可以幫助減輕疾病的症狀。
研究人員採用新的辦法來修飾血紅蛋白的另一個重要組分alpha球蛋白,這能夠幫助那些對藥物副作用反應太大或者對藥物不敏感的病人。這種治療方法可以同時和其他方法一起組合治療來幫助病人減輕疾病的困擾。
研究人員在攜帶鐮刀型細胞的轉基因小鼠中表達一種人類胚胎形式的血紅蛋白alpha鏈――zeta球蛋白。和患鐮刀型細胞的小鼠不同的是,改造後的轉基因小鼠血液中不再出現鐮刀型紅細胞,腎功能正常,有正常的血細胞計數,而不再是貧血,而且其紅細胞的壽命是正常紅細胞的5倍。這個工作證實一種全新的治療方法能夠逆轉患鐮刀型細胞貧血的小鼠的疾病進程。雖然這個實驗離套用到人還有相當遙遠的距離,不過可以預期,這種方法和其他現有的方法一起,將為飽受疾病折磨的病人提供更加有效而靈活的治療方案。
全世界有數以百萬計的人遭受鐮刀型貧血的困擾。這也是美國最常見的遺傳病,病人數大約在7.2萬左右,每500個非裔美國人中就有一個患者,每1000―1400西班牙裔美國人中就有一個患者,此外美國還有大約2百萬健康的鐮刀型貧血基因攜帶者,由於有潛在可能將疾病基因遺傳給子女而在接受治療。
預後:
本病的發展和後果如圖1所示。如果不經治療,視力降低至0.1者占12%。繼續發展則玻璃體積血發生率占28%~44% 將使視力明顯下降。經過治療的病例,如用氬雷射封閉新生血管,90%以上獲得成功,可減少玻璃體積血等併發症,預後一般較好。
飲食
1、宜多吃增強免疫作用的食物:甲魚、烏龜、海龜、沙蟲、青魚、鯊魚、水蛇、蝦、白花蛇、鯽魚、桑椹、無花果、荔枝、胡桃、瓜蔞、馬齒莧、豆豉、橄欖、杏仁、絲瓜。
2、宜多吃新鮮的水果和蔬菜。
3、宜多吃具有抗菌作用的食物,如蜂蜜、蘑菇等。
二、淚腺炎最好不要吃哪些食物?
1、忌酸辣之品。酸有收斂滯邪的作用,辣有辛竄發散的作用,如食李子、檸檬、山楂、梨、馬肉等酸性食品,弊大於利。辣椒、韭菜等辛辣之物最好不用。
2、忌偏食,該症病人多體虛,應食譜廣,偏食可使抗病能力減弱,不利康復。
3、忌咖啡、可可等興奮性飲料。
併發症
玻璃體積血及視網膜脫離等。

